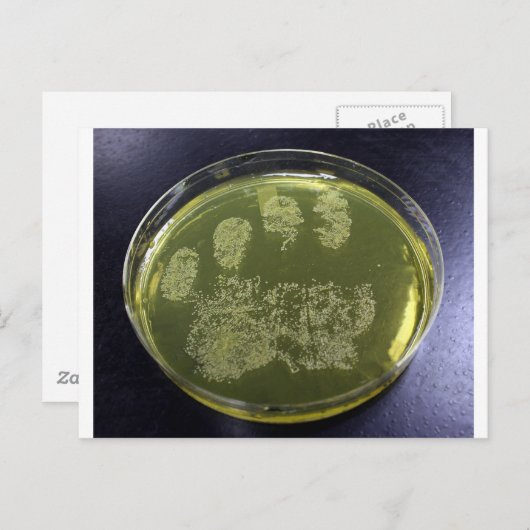
Carte Postale Bactéries à plat Petri à la main (Devant / Derrière)

A propos de Cartes postales
Vendu (e) par
À propos de ce design
Carte Postale Bactéries à plat Petri à la main
Une photo de Staphylococcus aureus poussant sur une assiette de gélose au sel de mannitol.
Traduction automatique
Avis des clients
4.4 sur 5 étoiles14 Nombres de Commentaires
14 Commentaires
Avis sur des produits similaires
5 sur 5 étoiles
Par Manon S.8 janvier 2022 • Achat sécurisé
Carte postale, Taille : Carte postale standard, Papier: Mat signature, Enveloppes: Aucun
Programme d'évaluation de Zazzle
Très jolie carte, amusante, resto comme verso. Bonne qualité d'impression, jolies couleurs.
5 sur 5 étoiles
Par Catherine D.21 novembre 2023 • Achat sécurisé
Carte postale, Taille : Carte postale standard, Papier: Mat signature, Enveloppes: Aucun
Programme d'évaluation de Zazzle
ravie de pouvoir encore trouver des cartes de saint Nicolas pour envoyer à mes petits enfants car elles sont introuvables en les libraires et carteries depuis quelques années. bonne impression et couleurs très douces
5 sur 5 étoiles
Par Catherine D.21 novembre 2023 • Achat sécurisé
Carte postale, Taille : Carte postale standard, Papier: Mat signature, Enveloppes: Aucun
Programme d'évaluation de Zazzle
ravie de pouvoir encore trouver des cartes de saint Nicolas pour envoyer à mes petits enfants car elles sont introuvables en les libraires et carteries depuis quelques années. jolies couleurs et très bonne impression
Tags
Autres infos
Identifiant du produit : 239851273002177006
Fabriqué le 24/12/2013 9:11
Évalué G
Articles vus récemment